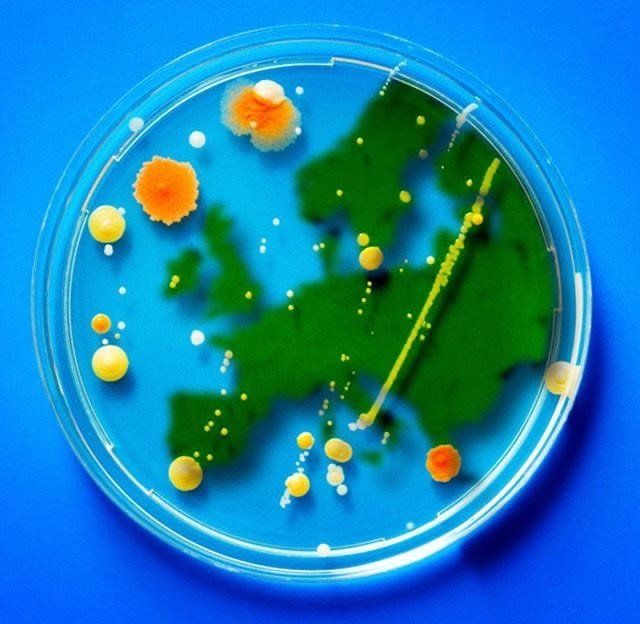

COVID ART MUSEUM
First virtual museum of Covid-19
No one doubts that the global Covid pandemic has marked a before and after, making changes not only in our routine, our economy and way of life, but that these changes have triggered our initiative and creativity.
Since all this began, innumerable artistic proposals have circulated on social networks, breaking the barriers of ‘social distance’, cultural and language differences, to sensitize ourselves and communicate in a universal way what this epidemic has meant for humanity.
This is how from the first days of confinement, three young Spanish creatives, Emma Calvo, Irene Llorca and José Guerrero, had the initiative to create a virtual museum, the Covid Art Museum CAM to collect works inspired by the coronavirus. The idea arose after realizing that the production of art in confinement was growing rapidly, not only in Spain but in the rest of the world, flooding the networks with many proposals. This type of work is framed in what has already been called Covid Art.
This first virtual museum of Covid-19 is based on an Instagram account (@CovidArtMuseum) that receives more than 200 works daily. In the words of its founders: ‘The main filter when choosing the pieces is that they are related to the current moment: the Covid-19 crisis. That is why we do not close ourselves to any technique, we collect all kinds of art, be it illustrations, photographs, painting, drawing, animations, video, etc.’
This is just a small sample of what you can find at the Covid Art Museum on their Instagram account, and it really deserves a visit ...